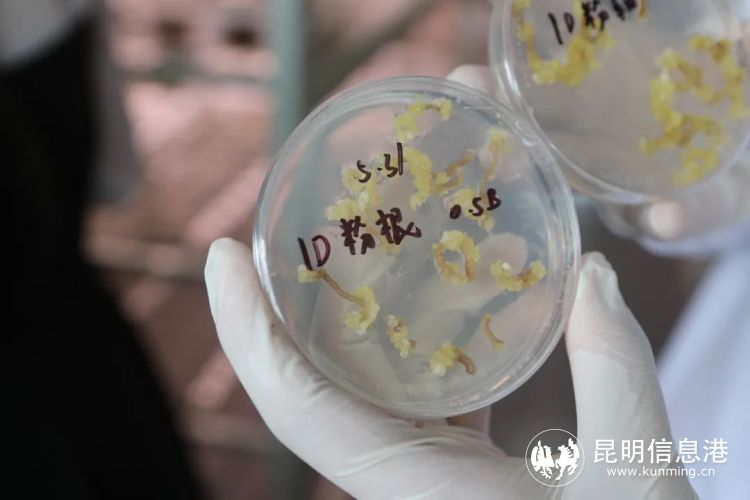

开篇语:
“当好排头兵,呈贡再冲刺”!6月24日,呈贡区开展“奋进新征程 建功新时代”暨“当好排头兵 呈贡再冲刺之第三期主题采访,围绕呈贡区如何以产业链精准布局人才链,组织媒体团深入一线进行重点宣传推介,解读呈贡区如何“引凤筑巢,为营商环境添动力”。
“项目+”“站(室)+”引才模式 助力产业转型升级
6月24日,位于呈贡斗南的国际花卉技术创新中心传来了好消息——经过科研团队对洋桔梗种子多种商业品种体细胞胚的诱导筛选,成功研发出能高效诱导体细胞胚形成的组培体系。通过该组培体系,1L培养基中可产生10万个胚体,即10万粒种子。这些胚状体通过后期培育和人工包衣后就成了和自然种子无异的人工种子,具有生产成本低、繁殖速度快、不受季节限制、保持品种优良遗传性状等特点。
国家观赏园艺工程技术研究中心共享实验室李帆博士说,科研团队在长期实践中深刻体会到花卉种业“卡脖子”问题,例如在云南花卉产业中占据重要地位的洋桔梗,其商业种子被日本公司垄断,比芝麻还小的洋桔梗种子市场价一粒就要0.6元,按照其0.05g的千粒重计算,一克种子约1.2万元,是黄金价格的30倍,堪比种子中的钻石。团队的技术突破,不仅打破了垄断,人工种子的应用也将解决洋桔梗种苗高效繁育的问题。

国际花卉技术创新中心是呈贡区联合云南省农业科学院花卉研究所共同建设的创新平台。比利时根特大学生物科学工程博士李帆是中心引进的花卉产业人才,他所在的博士团队共获国家科技进步二等奖1项、云南省科技进步一等奖6项等一系列创新成果。李帆说,之所以团队在科研成果上取得众多突破,除了斗南鲜花产业优势外,呈贡区的引才育才政策也是团队的坚强“后盾”。得益于呈贡区的人才政策的支持,团队能够安心在呈贡工作,今年也从比利时根特大学和上海交大引进了博士和博士后,充实了人才队伍。

据了解,近年来,呈贡区探索创新人才培养引进途径,实施产业人才培养行动,完善政产学研用相结合的引才育才模式,服务现代产业体系建设,以产业大发展促进人才大聚集,并以扶持人才项目、人才工作站(室)为抓手,构建“项目+”“站(室)+”的引才模式。5年来,与驻区高校、医院、企业合作,授牌认定人才工作站、专家基层工作站、博士工作站等工作载体近57个,立项扶持各领域人才项目108个,引进在全市、全省、全国各领域急需紧缺高层次人才百余人。
聚焦就业需求 打造品牌助力“人才留呈”
2021年2月,中共中央办公厅、国务院办公厅印发了《关于加快推进乡村人才振兴的意见》,提出“培育一批叫得响的农民工劳务品牌”。
在呈贡区的指导和扶持下,斗南花卉产业园区的——“昆明花匠”劳务品牌正发挥作用,帮助花农提升自有技能,解决就业问题,同时也帮助各类企业解决人才的选留问题。

云南斗南花卉产业集团执行总裁钱崇峻介绍:“我们对四千多户花农都上门对花卉种植进行技术上的支持和培训,组织花农来听农科院老师的讲课。对于花商主要是引导他们走集约化的路子,通过电商交易等金融扶持能够使他们的生意做得更大。带动花农的生产和花商的经营,持续获得收入的增加。“

据介绍,打造“昆明花匠”劳务品牌,旨在为全国提供了一个花卉人才交流的平台,为全国各地的鲜花从业者或想从事鲜花行业的人员提供大量的工作岗位,同时也为鲜花行业从业者提升职业技能提供技术支持,这对“人才留呈”将发挥积极的作用。
呈贡区就业局局长赵智佳介绍,呈贡区通过资金补助、政策引导等方式,鼓励辖区内企业积极开发就业岗位,为企业和务工人员“牵线搭桥”,发挥就业部门牵头协调作用,优化就业服务,通过举办“暖阳助企稳就业”专项志愿活动、春风行动、直播带岗等,采取灵活多样的形式,扎实做好“六稳六保”工作,及时掌握企业员工“招、引、培、留、用”情况,积极为企纾困解难,助力企业有序提升达产率,保障企业健康有序发展。
“真金白银”支持 让呈贡学子成为城市“合伙人”
为稳定高校毕业生就业“基本盘”,促进高校毕业生高质量就业。呈贡区启动了“大学生留呈计划”,结合“两园一市场”(昆明呈贡人力资源产业园、呈贡新区创业园和昆明呈贡大学生就业创业市场)和《呈贡区鼓励高校毕业生就业创业实施办法(试行)》,重点从设置人才服务窗口、岗位开发补助及个人工资补助、创业补贴、实习实训人员交通补贴和就业创业培训交通补贴等方面提出了扶持高校毕业生就业创业的政策措施,明确了“真金白银”的就业创业扶持。

在云南人民电力电气有限公司,记者获悉,今年5月,在云南交通职业技术学院举办的专场招聘会上,公司新招聘了52名电气自动化专业实习生,在公司进行为期一年的实习后,表现优异的学生将聘用为公司正式员工,解决公司人才梯队建设缺口。公司总经理章鹏介绍,呈贡区推动的“产才”融合发展战略,特别是政校企服务,为高校就业与企业人才引进提供了校企沟通合作平台。“通过校园招聘就成为呈贡大家庭的一员,为公司发展也奠定了基础,培养了一些技术型人才,公司未来上市会有更好的前途和发展。”

据悉,呈贡区启动“大学生留呈计划”相关政策执行至今,建立实习实训基地70家,提供就业实习岗位2500余个,发放个人工资补助138.86万元,岗位补助28.6万元;到实习实训基地实习大学生218人,发放交通补贴15.21万元;建立就业见习基地29个。推进企业招用毕业生3年高校生社会保险补贴、一次性吸纳补贴。其中,2021年至今年4月,呈贡区共兑付2022届高校毕业生求职创业补贴130人,共13万元。
争当昆明市产业发展排头兵,人才赋能产业是必须紧扣的一环。呈贡区深耕细作“人才沃土”赋能经济社会发展,人才红利新的优势逐步显现,呈贡区将在引才引智上再聚焦、在人才培育上再加力、在服务保障上再优化,吸引八方英才“留呈”,为推动经济社会高质量发展提供坚实支撑。(6686体育 记者段佳琪 通讯员刘洪斌 张金云 赵永刚)